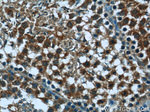
PEG10 Antibody in Immunohistochemistry (Paraffin) (IHC (P))
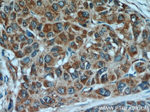
PEG10 Antibody in Immunohistochemistry (Paraffin) (IHC (P))
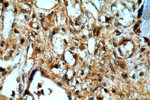
PEG10 Antibody in Immunohistochemistry (Paraffin) (IHC (P))

Search
Proteintech
PEG10 Polyclonal Antibody
{{$productOrderCtrl.translations['antibody.pdp.commerceCard.promotion.promotions']}}
{{$productOrderCtrl.translations['antibody.pdp.commerceCard.promotion.viewpromo']}}
{{$productOrderCtrl.translations['antibody.pdp.commerceCard.promotion.promocode']}}: {{promo.promoCode}} {{promo.promoTitle}} {{promo.promoDescription}}. {{$productOrderCtrl.translations['antibody.pdp.commerceCard.promotion.learnmore']}}
产品信息
14412-1-AP
种属反应
宿主/亚型
分类
类型
抗原
偶联物
形式
浓度
规格
纯化类型
保存液
内含物
保存条件
运输条件
产品详细信息
Immunogen sequence: MTERRRDEL SEEINNLREK VMKQSEENNN LQSQVQKLTE ENTTLREQVE PTPEDEDDDI ELRGAAAAAA PPPPIEEECP EDLPEKFDGN PDMLAPFMAQ CQIFMEKSTR DFSVDRVRVC FVTSMMTGRA ARWASAKLER SHYLMHNYPA FMMEMKHVFE DPQRREVAKR KIRRLRQGMG SVIDYSNAFQ MIAQDLDWNE PALIDQYHEG LSDHIQEELS HLEVAKSLSA LIGQCIHIER RLARAAAARK PRSPPRALVL PHIASHHQVD PTEPVGGARM RLTQEEKERR RKLNLCLYCG TGGHYADNCP AKASKSSPAG NSPAPL (1-325 aa encoded by B C050659)
靶标信息
This is a paternally expressed imprinted gene that encodes transcripts containing two overlapping open reading frames start codon, have been reported for this gene. Increased expression of this gene is associated with hepatocellular carcinomas.
仅用于科研。不用于诊断过程。未经明确授权不得转售。
生物信息学
蛋白别名: 2-Mar; embryonal carcinoma differentiation regulated; Embryonal carcinoma differentiation regulated protein; Embryonal carcinoma differentiation-regulated protein; mammalian retrotransposon-derived 2; Mammalian retrotransposon-derived protein 2; MEF3 like 1; MEF3-like protein 1; MmPEG10; MyEF-3; MyEF-3 like; Myelin expression factor 3; Myelin expression factor 3-like protein 1; Paternally expressed gene 10 protein; Retrotransposon gag domain-containing protein 3; retrotransposon Gag like 2; Retrotransposon-derived gag-like polyprotein; Retrotransposon-derived protein PEG10; Sushi-Ichi retrotransposon homolog 1; Ty3/Gypsy-like protein; unnamed protein product
基因别名: AA407948; EDR; HB-1; KIAA1051e; MAR2; MART2; MEF3L; MEF3L1; MyEF-3; PEG10; RGAG3; RTL2; SIRH1
UniProt ID: (Human) Q86TG7, (Mouse) Q7TN75
Entrez Gene ID: (Human) 23089, (Mouse) 170676